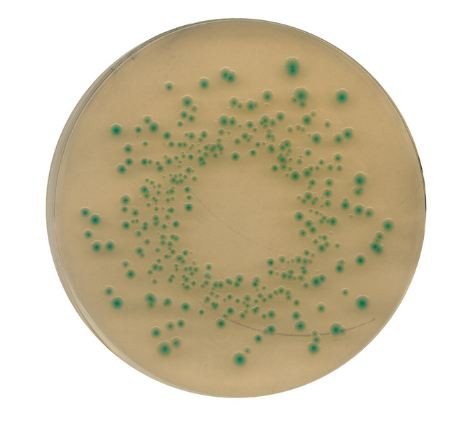

TBX (Tryptone Bile X-glucuronide) agar Merck
0 ₫
TBX (Tryptone Bile X-glucuronide) agar, code: 1114710500, xuất xứ: Merck – Đức. Là chất rắn màu vàng. Hóa chất được sử dụng để xác định và làm giàu vi khuẩn Escherichia coli trong mẫu thực phẩm, thức ăn chăn nuôi và nước, ứng dụng trong tổng hợp, phân tích vi sinh tại phòng thí nghiệm trường học, viện nghiên cứu,…Quy cách đóng gói: Chai nhựa 500g.

Đánh giá
Chưa có đánh giá nào.